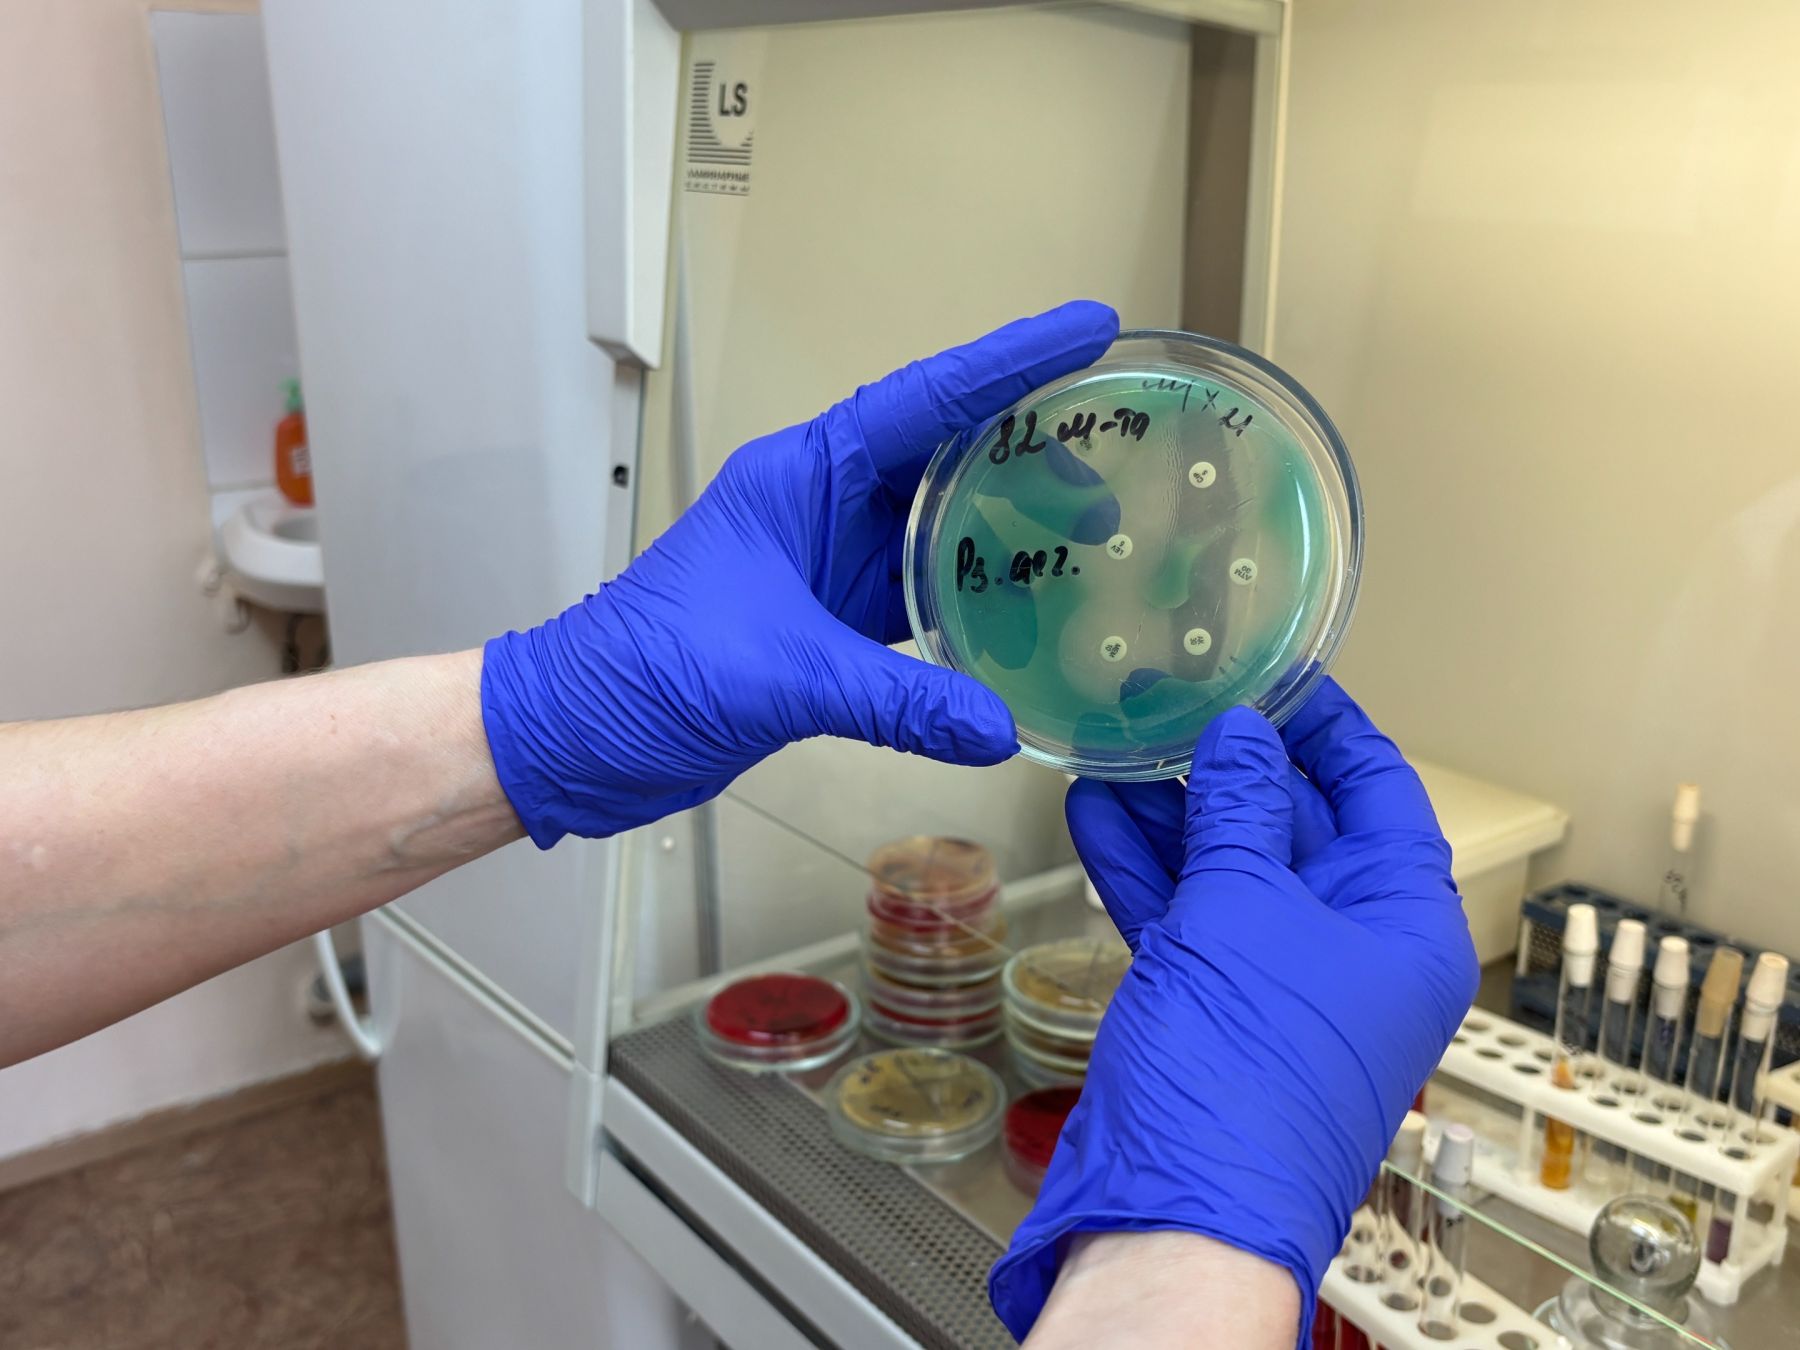
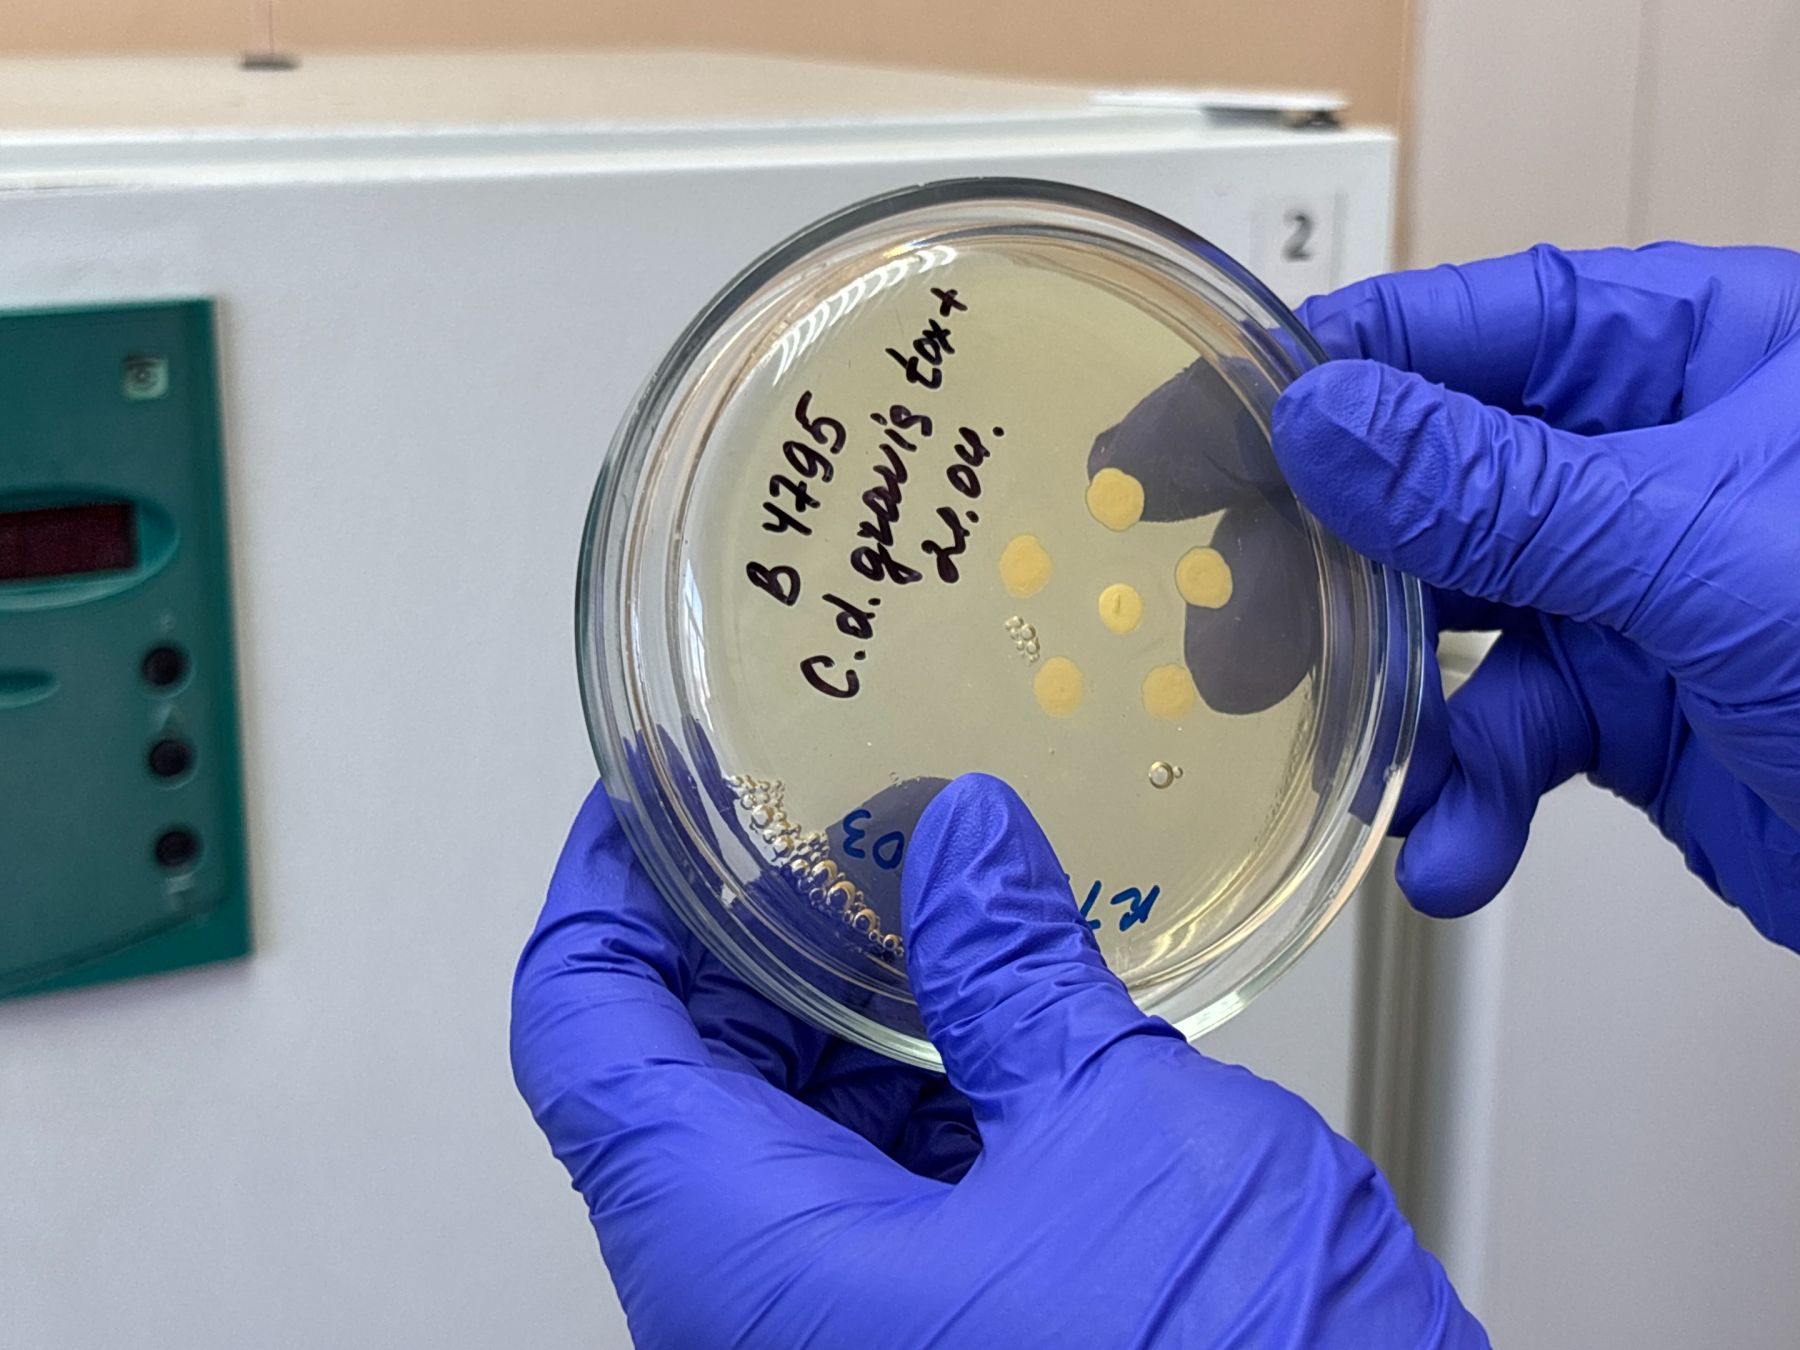
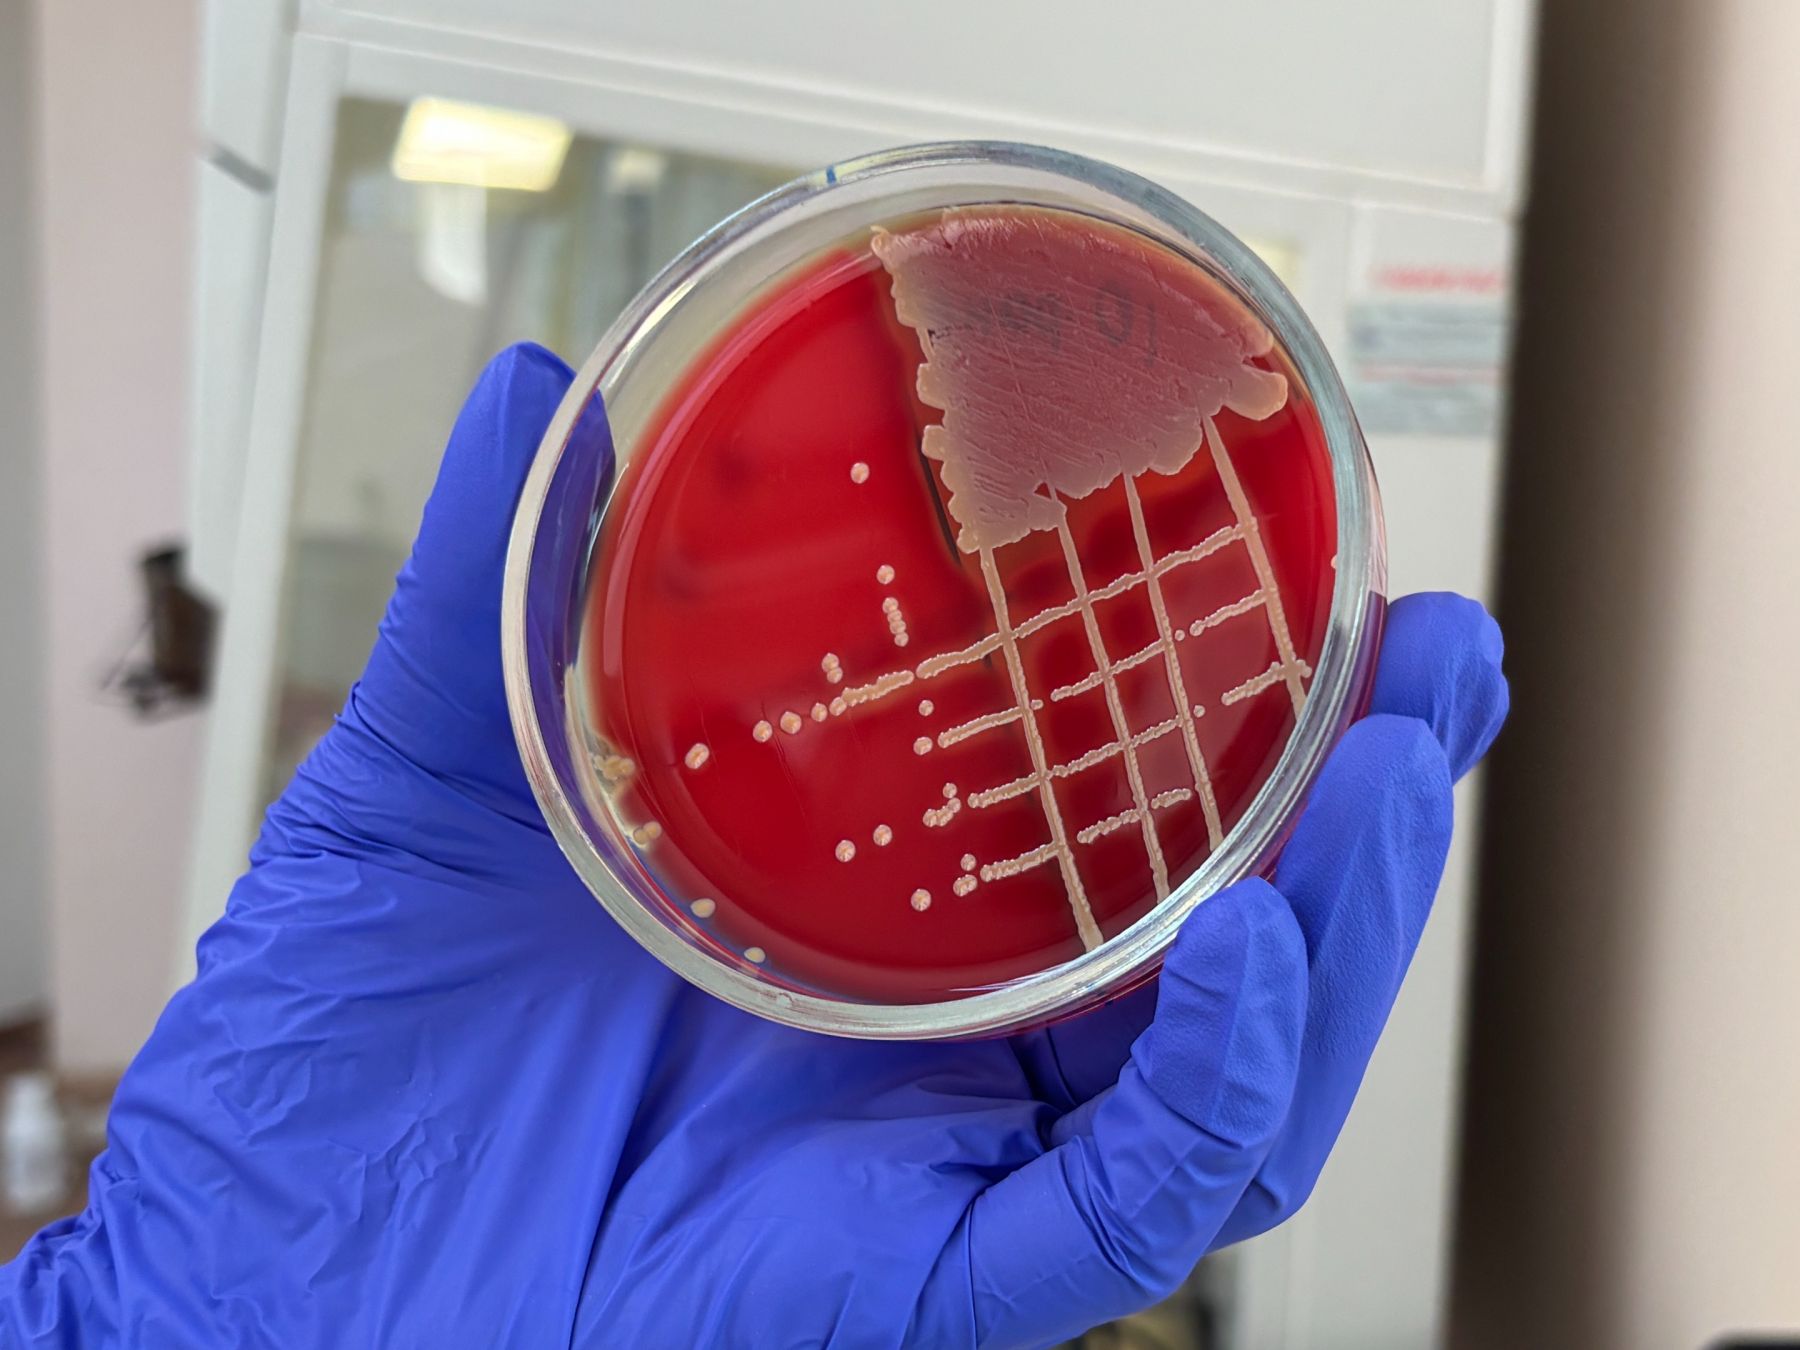

Врач-бактериолог рассказала, можно ли есть немытые фрукты и овощи прямиком с грядки
В Бийске на базе городской больницы №2, расположенной по ул. Разина, есть отделение, где врачи изучают состояние здоровья человека на микробиологическом уровне. Здесь находится бактериологическая лаборатория, куда отчасти попадают анализы пациентов.
Из чистой зоны в грязную
Больше 10 лет Альбина Жданова, врач-бактериолог и заведующая бактериологической лабораторией, помогает врачам, работающим в больницах нашего города, определить возбудителя воспалительных процессов в организме у пациента по анализам и подобрать чувствительный антибактериальный препарат для его лечения.

- Мы ищем патогенные и условно-патогенные микроорганизмы, которые послужили причиной заболевания. Наша лаборатория ограничивается выявлением факультативных анаэробов и аэробов. Это означает, что есть и другие бактерии, которые живут без кислорода, а также внутриклеточные микроорганизмы, с которыми мы не работаем, - рассказала врач. - В нашем оснащении качественные питательные среды и диагностические системы, благодаря чему даже без автоматизации идентификация возбудителя происходит в короткие сроки. И огромную благодарность я хочу сказать нашему коллективу. Именно в связке врач- фельдшер-лаборант - санитарка мы можем качественно выдать результат. А вот преаналитический этап иногда вносит погрешности в нашей работе.
Высеваются разные микроорганизмы. Золотистый стафилококк, энтерококки, клебсиелла, кишечная палочка, синегнойная палочка, кандиды - частые гости, которые живут на наших чашках Петри. Патогенные стрептококки и сальмонеллы не так часто высеваются от пациентов. А возбудители дизентерии, коклюша и дифтерии в последние годы не выделяются.
Помимо этого, в лаборатории делают бактериологические смывы с различных поверхностей в помещениях больницы. Исследуется воздух и контролируется стерильность материалов и инструментов. Так они следят за чистотой во всем медицинском учреждении, ведь бактерии живые и обитают повсюду.
Сама лаборатория разделена на две зоны: чистую и грязную. В первой - происходит подготавливание сред и посуды, куда будет производиться посев бактерий.
Основа плотной питательной среды - агар-агар. Да-да, именно тот агар из водорослей, который используется для приготовления мармелада. К агару добавляются разные добавки и чашки Петри получаются разного цвета: в кровяной агар - добавляют кровь, в желточно-солевой – яйцо и соль, а шоколадный агар свое название получил за красивый шоколадный цвет. Но это не шоколад или какао, это гретая кровь.

- За чистой зоной находится грязная, где обитают бактерии. Биологический материал, например, слюна, мокрота, кровь или различные мазки поступают именно сюда. В зависимости от того, что мы хотим выявить, происходит посев бактерий, - поделилась специалист.
Для работы с посевами используется бактериологическая петля и спиртовка. После работы с каждой колонией петлю необходимо обжечь и остудить - показала наглядно врач.
Земляничный аромат
После посева чашки Петри на сутки помещаются в специальные боксы - термостаты, где поддерживаются благоприятные условия для роста бактерий и грибов. Чаша с «шоколадной» субстанцией помещается в эксикатор. Ведь именно там для пневмококка будут наиболее благоприятные условия для роста. Через время, казалось бы, чистая среда, начинает покрываться пятнышками. Каждая бактерия делится и дает потомство - так появляется уже видимая глазу колония.

- Бактерии повсюду – в окружающей среде и даже в самих людях. В организме 70-килограммового человека находится около 1,5 кг различных бактерий, грибов, вирусов и паразитов. Есть нормальные, безобидные, а есть условно-патогенные. Например, кандида. Она живет в кишечнике и ее количество до 1000 в 1 мл материала не вызывает заболеваний. Если иммунитет ослабевает или в организм попадет бактерия-возбудитель, количество кандиды возрастает и это может вызвать процесс брожения, нарушение пищеварения или интоксикацию, - рассказала Альбина Александровна.

К слову, бактерии все разные по размеру и цвету. Некоторые даже имеют свой специфический запах. Например, синегнойная палочка. Цвет колоний на питательной среде полностью соответствует названию – здесь есть синий оттенок и немного зеленого. А вот запах на удивление приятный. Аромат синегнойной палочки напоминает политую дождем лесную землянику.
- Для того, чтобы определить вид бактерий, я посеяла ее в пробирку с агара. Через сутки посмотрю ее морфологию в микроскоп и сделаю биохимические тесты. Посмотрю, что утилизирует бактерия, подвижна она или нет. Поставлю дополнительные тесты при необходимости. Очень помогают хромагары - коммерческие питательные среды с индикатором. Для идентификации одного микроогранизма иногда нужно до 8-10 тестов. И все это делается вручную, - пояснила врач.

Рассмотрев бактерии поближе под микроскопом, можно увидеть их форму: одни – круглые, другие более вытянуты, похожие на палочки, толстые и тонкие.

Умные бактерии
Так на протяжении пяти дней с микроорганизмы тщательно изучают. Специалисты сами себя проверяют, чтобы не допустить ошибки в исследованиях. Каждый день проводится внутренний контроль сред и биохимических тестов нужными проверенными бактериями.
Только после тщательного изучения бактерии засевают на особую среду для определения чувствительности. Для этого кладут диски, пропитанные различными антибиотикам. Так для возбудителей подбирают эффективные препараты, которые способны их погубить. Затем в специальных бланках делаются пометки о чувствительности бактерии к тому или иному антибиотику, а после эти данные передаются врачу, который принимает решение о коррекции или продолжении лечения человека антибиотиками.
- Бактерии – довольно умные существа. Они умеют приспосабливаться к антибиотикам, которые могут их уничтожить. Также они мутируют, становясь более устойчивыми к препаратам. Поэтому важно правильно подбирать лечение. Также вирусные заболевания незачем лечить антибиотиками. А многие люди, вроде простыли, появился насморк, начинают пить антибиотики, которые есть в аптечке. Но ведь так они понижают свой иммунитет, цепляют еще каких-нибудь возбудителей и усугубляют ситуацию, - пояснила врач.
Как утверждает врач, необдуманное применение антибиотиков может нарушить иммунитет, повредить "полезные бактерии" и увеличить процесс восстановления после заболевания.

- К слову, большая часть иммунитета находится в кишечнике, - отметила Альбина Александровна. - Для этого важно есть не только то, что хочется, но и думать о "братьях наших меньших". Думать, что полезно это для них, а что нет. Очень часто по анализам видим, что количество лактобактерий и бифидобактерий в кишечнике у пациентов с дисбактериозами сильно снижено.
Болезнь немытых рук
Многие привыкли думать, что весна - время для пробуждения различных болезней. Однако у бактерий есть своя сезонность. Так, зимой чаще высевается пневмококк, весной – золотистый стафилококк, а летом – синегнойная палочка. А если съесть немытые фрукты овощи или ягоды прямиком с грядки?

- Раньше использовали очень мало пестицидов и различных химикатов. Поэтому в почве жили полезные бактерии - антагонисты патогенам. Например, Bacillus subtilis (сенная палочка) – сейчас на ее основе делают лекарственные вещества и удобрения. Однако тут еще важную роль играет иммунитет, - рассказала специалист.
Убийственные условия
Убийственным для всех бактерий является высокая температура и высокое давление. Именно так их утилизируют в лаборатории. Чаши и сосуды с одержимым помещают в автоклавы, где температура 121-134°C, а давление: 1,1-2 атм. После чего все моется и стерилизуется.

Как утверждает врач, в лаборатории за микроорганизмами нужно ухаживать, как за урожаем на грядках. Если оставить, например, помидоры в теплице на несколько дней без присмотра, то они засохнут. Тогда их придется реанимировать. То же самое происходит и с бактериями.
- Если посевы на чашках с бактериями оставить на несколько дней в термостате, то среда истощится, за сохнет, и микроорганизмы на ней тоже. Бактерии исчерпывают из нее все питательное. Например, стрептококки без присмотра погибнут, они очень нежные, а вот синегнойная палочка и кандиды будут прекрасно себя чувствовать. Они не привередливые и могут спокойно пережить несколько дней без присмотра. Менингококк и гемофильная палочка особо нежные и чувствительные, наверное, из того, с чем мы работаем, - сообщила врач.
Рекомендации по защите от бактерий
Согласно рекомендациям бактериологов, чтобы защититься от патогенных бактерий в повседневной жизни, нужно соблюдать ряд простых процедур:
- Мыть руки, почаще производить влажную уборку в помещении и быть на свежем воздухе.
- Важно проветривать помещение, в котором вы находитесь. Но нужно это делать качественно: выйти из помещения и открыть полностью окна на 10 минут, чтобы весь воздух полностью сменился.

Как оказалось, в первую очередь бактерии садятся на слизистую. Чтобы полечить нос или горло, сначала нужно смыть слизь: именно под этой "шубой" кроются микроорганизмы, вызывающие заболевание. Потом уже можно применять лекарства.












А чо нельзя-то ? Выдернул морковку, отряхнул да и хрумкай себе на здоровье !